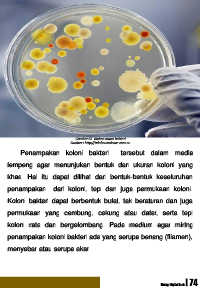

Page 79 - SELAMAT DATANG DI BIOLOGY DIGITAL BOOK
P. 79
Gambar 65. Biakan murni bakteri
Sumber : http://adaboutscience.com.au
Penampakan koloni bakteri tersebut dalam media
lempeng agar menunjukan bentuk dan ukuran koloni yang
khas. Hal itu dapat dilihat dari bentuk-bentuk keseluruhan
penampakan dari koloni, tepi dan juga permukaan koloni.
Koloni bakteri dapat berbentuk bulat, tak beraturan dan juga
permukaan yang cembung, cekung atau datar, serta tepi
koloni rata dan bergelombang. Pada medium agar miring
penampakan koloni bakteri ada yang serupa benang (filamen),
menyebar atau serupa akar.
Biology Digital Book | 74